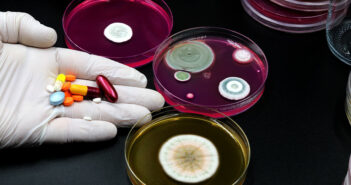

Továbbra is a kozmetikumok vezetik a veszélyes, nem élelmiszeripari termékek listáját
A veszélyes, nem élelmiszeripari termékek uniós gyorsriasztási rendszerében kozmetikai termékekre és játékokra érkezett a legtöbb…

A veszélyes, nem élelmiszeripari termékek uniós gyorsriasztási rendszerében kozmetikai termékekre és játékokra érkezett a legtöbb…
A Szegedi Tudományegyetem (SZTE), a temesvári Victor Babeş Orvosi és Gyógyszerészeti Egyetem és az OncoHelp…

Világszerte minden tizedik nőt érint az endometriózis, mégis gyakran éveket késik a diagnózis. A Női…
